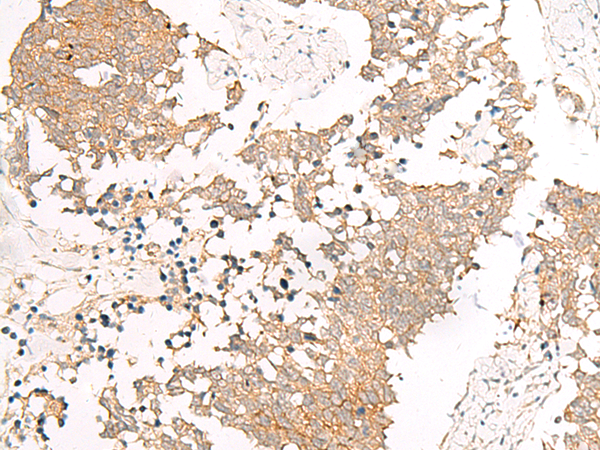

-
分类: 科研抗体货号: P13408别名: FPN1; HFE4; MTP1; IREG1; MST079; MSTP079; SLC11A3应用: IHC反应种属: Human
-
分类: 科研抗体货号: P13407别名: PTFB; NATO3; NTWIST; N-TWIST; bHLHa31应用: IHC反应种属: Human
-
分类: 科研抗体货号: P13425别名: HFH3; FKH10; HFH-3; FKHL10; FREAC6; FREAC-6应用: WB,IHC反应种属: Human
-
分类: 科研抗体货号: P13406别名: TYK3; PPP1R74; p94-Fer应用: IHC反应种属: Human, Mouse, Rat
-
分类: 科研抗体货号: P13442别名: GAL2-R; GALNR2; GALR-2应用: IHC反应种属: Human, Mouse, Rat
-
分类: 科研抗体货号: P13424别名: FAST1; FAST-1应用: IHC反应种属: Human
-
分类: 科研抗体货号: P13435别名: mER; CEPR; GPER; DRY12; FEG-1; GPR30; LERGU; LyGPR; CMKRL2; LERGU2; GPCR-Br应用: IHC反应种属: Human, Mouse, Rat
-
分类: 科研抗体货号: P13441别名: GALNR; GALNR1应用: IHC反应种属: Human, Mouse, Rat
-
分类: 科研抗体货号: P13423别名: JUNO; FOLR4; Folbp3应用: IHC反应种属: Human
-
分类: 科研抗体货号: P13434别名: GBL; LST8; POP3; WAT1; GbetaL应用: WB反应种属: Human, Mouse, Rat

鄂公网安备42018502007531号
鄂公网安备42018502007531号

